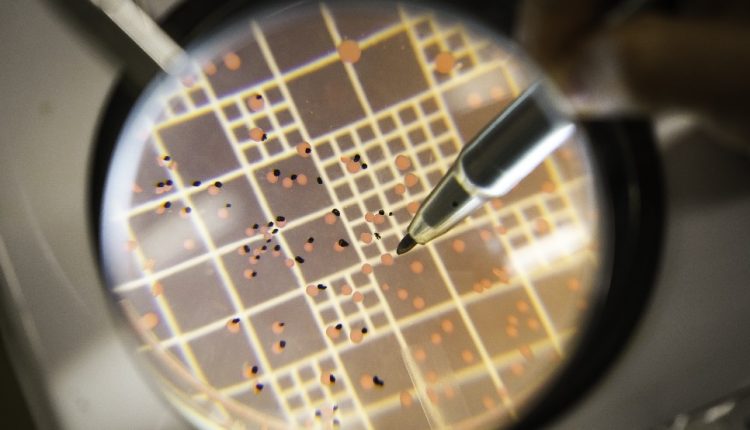

Durante dez anos, a Embrapa Soja conduziu ensaios a campo para avaliar a inoculação em 12 genótipos comerciais (híbridos e variedades) de milho.
A Embrapa Soja vai participar do Show Rural Coopavel, a ser realizado de 06 a 10 de fevereiro, em Cascavel (PR), apresentando na Vitrine de Tecnologias, as vantagens da adoção de inoculantes tanto no milho quanto no capim braquiária. No caso do milho, os resultados de pesquisas indicam que sementes inoculadas com a bactéria Azospirillum brasilense (estirpes Ab-V5 e Ab-V6) tem possibilidade de redução de 25% da adubação nitrogenada de cobertura, considerando a dose de 90 quilos (kg) por hectare de N-fertilizante.
A tecnologia de inoculação do milho com a bactéria Azospirillum brasilense propicia redução na adubação nitrogenada de cobertura e ainda permite um incremento médio de 3,1% na produtividade de grãos.
Durante dez anos, a Embrapa Soja conduziu ensaios a campo para avaliar a inoculação em 12 genótipos comerciais (híbridos e variedades) de milho com as estirpes Ab-V5 e Ab-V6 de A. brasilense. O pesquisador Marco Antonio Nogueira, da Embrapa Soja, explica que as plantas receberam a mesma adubação de base com macro e micronutrientes e a inoculação foi realizada na semeadura, quando também foram aplicados 24 kg/ha de nitrogênio (N).

Segundo ele, ao redor dos 35 dias após a emergência do milho, foram fornecidos 0%, 50%, 75% e 100% de N em cobertura, sendo 100% correspondente a 90 kg/ha de nitrogênio, aos tratamentos inoculados e não inoculados. “O rendimento de grãos das plantas inoculadas e com 75% da adubação nitrogenada em cobertura foi igual ao das plantas não inoculadas e que receberam 100% da adubação nitrogenada, o que indica ser possível reduzir a adubação nitrogenada de cobertura em 25%, sem perda de produtividade”, comemora Nogueira.
Inoculação das braquiárias
A tecnologia de inoculação multifuncional de pastagens, que associa microrganismos com propriedades multifuncionais (Azospirillum brasilense e Pseudomonas fluorescens), tem potencial para aumentar, em média, em 22% a produção das pastagens com braquiárias, além de ampliar a absorção de nutrientes pelas plantas. De acordo com os pesquisadores da Embrapa Soja, Mariangela Hungria e Marco Antonio Nogueira, além de incrementar a produção de biomassa pelas forragens, a inoculação com microrganismos incrementa a absorção de nitrogênio (N), fósforo (P) e potássio (K).
No caso da bactéria Azospirillum, os principais processos microbianos envolvidos são a síntese de fitormônios, promovendo o crescimento das raízes em até três vezes; e a fixação biológica do nitrogênio. A inoculação com essas bactérias via sementes ou via foliar em pastagens estabelecidas resultou, além do incremento na biomassa, em aumento médio de 13% no teor de N e de 10% no de K na parte aérea. Por sua vez, a Pseudomonas contribui com um conjunto de processos bioquímicos que incluem a solubilização de fosfatos, a síntese de fitormônios e de uma enzima reguladora da produção de etileno.
A inoculação via sementes ou foliar com Pseudomonas resultou em incremento na biomassa, de 11% no teor de potássio (K) e de 30% no de fósforo (P) na parte aérea. Vale destacar que o desenvolvimento da tecnologia procurou viabilizar o sinergismo entre os microrganismos e permite a aplicação tanto na fase de estabelecimento de pastagens, quanto em pastagens já estabelecidas.
- Nelore com marmoreio surpreende especialista: “nova realidade” da carne no Brasil
- O Seguro-Safra que não custa um centavo: Como o diferimento protege seu bolso na entressafra
- Suplementação de bovinos nas águas: vale a pena?
- BNDES vai destinar R$ 10 bilhões em novas linhas de crédito voltadas à indústria brasileira
- Fenasul Expoleite projeta recorde de animais e inicia definição da programação
Recuperação de pastagens
No Brasil, cerca 180 milhões de hectares são ocupados por pastagens, sendo 120 milhões com pastagens cultivadas, dos quais 86 milhões com braquiárias. De acordo com levantamento da Embrapa, aproximadamente 70% das pastagens brasileiras encontram-se em algum estágio de degradação, produzindo abaixo de seu potencial. “Não é, portanto, o momento de diminuir o uso de fertilizantes nas pastagens, mas sim de usar o potencial dos microrganismos para incrementar a eficiência de uso desses fertilizantes”, destaca Nogueira.
Como uma grande contribuição dessas bactérias ocorre pela promoção do crescimento das raízes, as plantas absorvem mais água e nutrientes, aproveitando melhor os fertilizantes. “Hoje o Brasil importa, aproximadamente, 85% do N-P-K que consome, de modo que o aumento na eficiência de uso dos fertilizantes pode promover grande impacto para o setor”, ressalta Nogueira.
Fonte: Ascom Embrapa Soja
Quer ficar por dentro do agronegócio brasileiro e receber as principais notícias do setor em primeira mão? Para isso é só entrar em nosso grupo do WhatsApp (clique aqui) ou Telegram (clique aqui). Você também pode assinar nosso feed pelo Google Notícias
Não é permitida a cópia integral do conteúdo acima. A reprodução parcial é autorizada apenas na forma de citação e com link para o conteúdo na íntegra. Plágio é crime de acordo com a Lei 9610/98.
